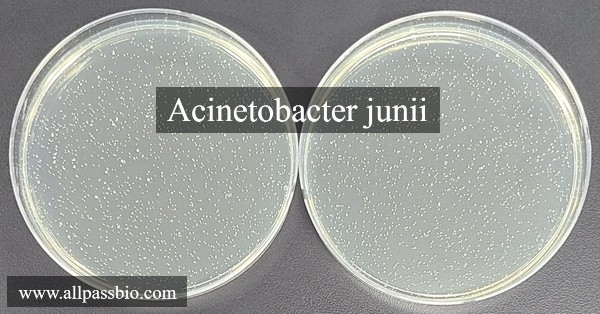

미생물에 의한 방광염의 경우
Escherichia coli, Acinetobacter junii, Acinetobacter schindleri, Enterococcus faecalis, Staphylococcus saprophyticus, Zimmermannella alba와 질염 을 유발하는 것으로 알려져 있는 Gardnerella vaginalis 등에 의해서 발생됩니다.
https://blog.naver.com/allpassbio/223097429816